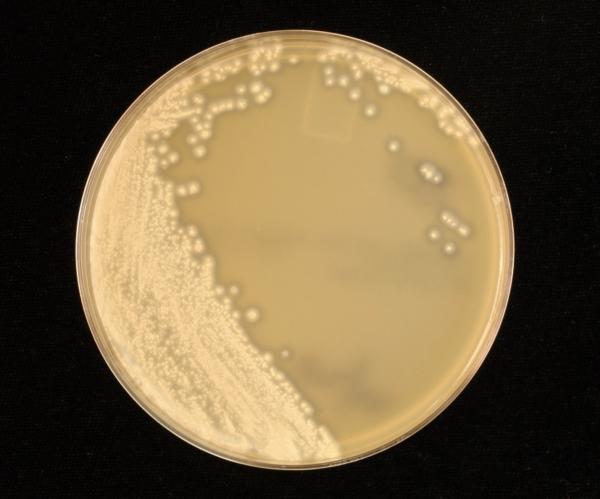
ACSH article image

More than likely, you are well acquainted with Strep throat testing. You know - when the super dry tongue depressor presses your tongue down so that the Q tip can reach the back of your throat - so far in the back that you gag a little.
The Q tip is picking up the bacteria that are in the back of your throat. When cultured, it will either reveal the presence of Streptococus pyogenes, the main cause of strep throat, or not. Sometimes, in about 5% of cases, the cause of the sore throat is another type of Streptococccus (C or G.)
But, a case in Minnesota recently had all of the symptoms of strep throat, without the strep. What was the cause? In this case, the throat swab sent for further testing revealed the bacterium Fusobacterium necrophorum. F. necrophorum is a gram-negative bacteria that causes Lemierre syndrome, an infrequent but scary case of an infection that can become deadly. The "forgotten disease," as it is often called, is a complication of the infection, that results in clots in the blood vessels.
It turns out that strep throat caused by F. necrophorum may not be so rare after all. In one study, it was found in 20.5% of patients at a university with pharyngitis. Interestingly, in another study, only 1.9% of pharyngitis patients under 14 years old were positive for F. necrophorum. This is a stark distinction from the 13.5% in the 14 to 20 year age range. However, the bacteria it is difficult to culture because it requires a specific type of media. Therefore, it may be under-diagnosed.
The lack of recognition of this bacteria in cases of Strep throat is important, mainly due to how Strep throat is treated. These same antibiotics that will kill Streptococcus will not necessarily work on Fusobacterium. The antimicrobials that are likely to be used for an infection of Fusobacterium are metronidazole or a beta-lactam combination agent such as amoxicillin-clavulanate. If common antibiotics for Streptococcus are used instead, the untreated Fusobacterium infection will increase the potential for Lemierre syndrome - something far worse than a sore throat.
Source: https://www.asm.org/index.php/clinmicro-blog/item/7227-more-than-just-st...